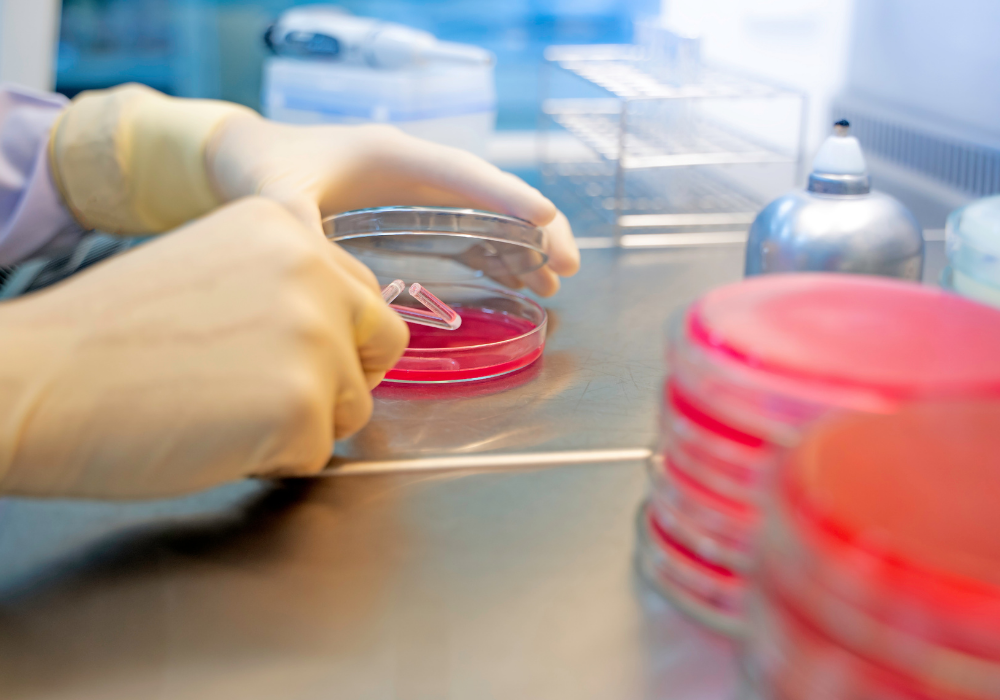

Tortora et al. (2012) descreve que, os estafilococos são bactérias gram-positivas esféricas que formam agrupamentos irregulares como cachos de uva, sendo que o
Staphylococcus aureus é o mais patogênico dos estafilococos.
Tipicamente, forma colônias amarelo-douradas, e essa pigmentação é um fator protetor contra os efeitos antimicrobianos da luz solar (TORTORA et al., 2012).
Indivíduos saudáveis são frequentemente portadores, e estafilococos residentes no trato respiratório superior ou na pele raramente causam doença. Durante a primeira semana de vida, os bebês geralmente são colonizados pela mãe ou por outro contato humano próximo (MADIGAN et al. 2014).
Forsythe (2013) cita que, os estafilococos existem no ar, na poeira, no esgoto, na água, no leite e nos alimentos ou equipamentos para processar alimentos, nas superfícies expostas aos ambientes, nos seres humanos e nos animais. As bactérias do gênero
Staphylococcus são cocos Gram-positivos, pertencente à família
Micrococcaceae e por dividirem em planos diferentes, quando vistos ao microscópio aparecem na forma de cacho de uva. A espécie S. aureus é a que está associada mais frequentemente às doenças estafilocócicas, quer sejam de origem alimentar ou não (FRANCO e LANDGRAF, 2008).
As espécies de estafilococos são hospedeiro-adaptadas, e meteda deas esécies conhecidas habitam somente humanos (p. ex.,
S. chnii subsp. Cohnii) ou humanos e outros animais (p. ex.,
S. aureus). Um maior número tende a ser encontrado próximo a aberturas do corpo e superfícies da pele (JAY, 2005).
Características gerais de crescimento (multiplicação)
Os estafilococos são bactérias mesófilas apresentando temperatura de crescimento na faixa de TC a 47,8°C; as enterotoxinas são produzidas entre 10°C e 46°C, com ótimo entre 40°C e 45°C (FRANCO e LANDGRAF, 2008).
Jay (2005) cita que, embora sejam mesófilas, algumas linhagens de S. aureus podem crescer a temperaturas de até 6,7°C.
Franco e Landgraf (2008) descrevem que, as bactérias do gênero são tolerantes a concentrações de 10%a250% de NaCl e a nitratos, o que torna os alimentos curados veículos potenciais para as mesmas.
Considerando o pH, o
S. aureus pode multiplicar-se entre 4,0 a 9,8, mas sua faixa ótima está entre 6,0 a 7,0 (JAY, 2005).
Em relação à atividade de água (Aa), Franco e Landgraf (2008) citam que, os estafilococos são únicos em sua capacidade de crescerem em valores inferiores aos normalmente considerados mínimos para as bactérias não-halófilas. O valor mínimo de Aa considerados, atualmente, é de 0,86 apesar de, sob condições ideais, esta bactéria já ter se desenvolvido em Aa de 0,83.
O
S. aureus é uma bactéria anaeróbia facultativa (FORSYTHE, 2013).
Hábitat do Staphylococcus aureus
Os estafilococos existem no ar, na poeira, no esgoto, na água, no leite e nos alimentos ou equipamentos para processar alimentos, nas superfícies expostas aos ambientes, nos seres humanos e nos animais. Os humanos e os animais são os principais reservatórios. Os estafilococos estão presentes nas vias nasais e na garganta e também no cabelo e na pele de 50% ou mais dos indivíduos saudáveis (FORSYTHE, 2013).
Segundo Franco e Landgraf (2008), o homem e os animais são os principais reservatórios de
S. aureus. A cavidade nasal é o principal hábitat dos estafilococos no homem e, a partir deste foco, atingem tanto a epiderme e feridas como o ar, água, solo, leite, esgoto e qualquer superfície ou objeto que tenha entrado em contato com o homem.
Formas de contaminação dos alimentos por Staphylococcus aureus:
Os portadores nasais e os manipuladores de alimentos com mãos e braços que apresentam feridas infectadas com
S. aureus são importantes fontes de contaminação dos alimentos (FRANCO e LANDGRAF, 2008).
Apesar de os manipuladores de alimentos serem normalmente as principais fontes de contaminação dos alimentos, quando há surtos, os equipamentos e as superfícies também podem ser a fonte das contaminações
S. aureus (FORSYTHE, 2013).
Alimentos que requerem manuseio considerável durante o preparo, e são mantidos ligeiramente acima das temperaturas de refrigeração adequadas por um longo período após o preparo, estão frequentemente envolvidos em intoxicação alimentar estafilocócica (ABRAHAM et al., 2012).
Quais são os sintomas da doença?
Os sintomas de intoxicações causadas por estafilococos aparecem com rapidez e incluem: náuseas, vômitos e cólicas abdominais (FORSYTHE, 2013). Podem ocorrer ainda dores de cabeça, calafrios, queda de pressão arterial e, raríssimas vezes, febre, quando a quantidade de toxina ingerida é grande (FRANCO e LANDGRAF, 2008).
S. aureus causa intoxicação provocada pela ingestão do alimento que apresenta a toxina pré-formada. Portanto, o agente causal não é a bactéria per se, mas várias toxinas (A, B, C1, C2, D, E) produzidas por esta bactéria, conhecidas como enterotoxinas (FRANCO e LANDGRAF, 2008).
A SEA é a toxina que costuma estar mais associada com intoxicações causadas por
Staphylococcus (cerca de 77% dos surtos), e é codificada por um bacteriófago temperado (FORSYTHE, 2013).
Certas cepas de
Staphylococcus aureus são responsáveis pela síndrome do choque tóxico (TSS do inglês
Toxic Shock Syndrome), um resultado grave da infecção estafilocócica, caracterizada por febre alta, erupções cutâneas, vômitos, diarréia e morte (MADIGAN et al. 2014).
É importante destacar que, atualmente a legislação brasileira prevê a pesquisa de enterotoxina estafilocócica em várias categorias de alimentos, que devem ser monitorados justamente pelo fato de que o microrganismo
S. aureus é destruído na maioria dos processos de fabricação dos alimentos através do emprego de tratamento térmico (pasteurização, por exemplo), porém as enterotoxinas conforme descrito por Franco e Landgraf (2008), são termorresistentes, tal fator é especialmente importante para indústria de alimentos, porque a maioria dos alimentos processados sofre algum tratamento térmico durante o processamento.
Frosythe (2013) cita que, uma dose de toxina menor que 1,0 µg/kg (300 a 500 ng) em alimentos contaminados produzirá sintomas de intoxicação por estafilococos. Essa quantidade de toxina é produzida por 105 micro-organismos por grama.
No Brasil, os alimentos que devem ser monitorados quanto à presença de enterotoxina estafilocócica encontram-se listados nos anexos da
Instrução Normativa 60/2019 – ANVISA.
Microbiologia em alimentos: o que é e qual a sua importância
Como podemos te ajudar?
 Por: Keli Lima Neves, Ederson Josué dos Santos
REFERÊNCIAS
Por: Keli Lima Neves, Ederson Josué dos Santos
REFERÊNCIAS:
- FORSYTHE, S. J. Microbiologia da segurança dos alimentos. 2 ed. Porto Alegre: Artmed, 2013
-
- FRANCO, Bernadette D. Gombossy de Melo; LANDGRAF, Mariza. Microbiologia dos alimentos. São Paulo: Atheneu, 2008.
-
- JAY, J. M. Microbiologia dos Alimentos. 6 ed. Porto Alegre: Artmed, 2005.
-
- MADIGAN, M.T.; MARTINKO, J.M.; DUNLAP, P.V.; CLARK, D.P. Microbiologia de Brock. 12 ed. Porto Alegre: Artmed, 2010. 1160 p.
-
- Food and Drug Administration. Bad Bug Book, Foodbornen Pathogenic Microorganisms and Natural Toxins. Second Edition. 2012.
Por: Keli Lima Neves, Ederson Josué dos Santos
REFERÊNCIAS:
Por: Keli Lima Neves, Ederson Josué dos Santos
REFERÊNCIAS:
